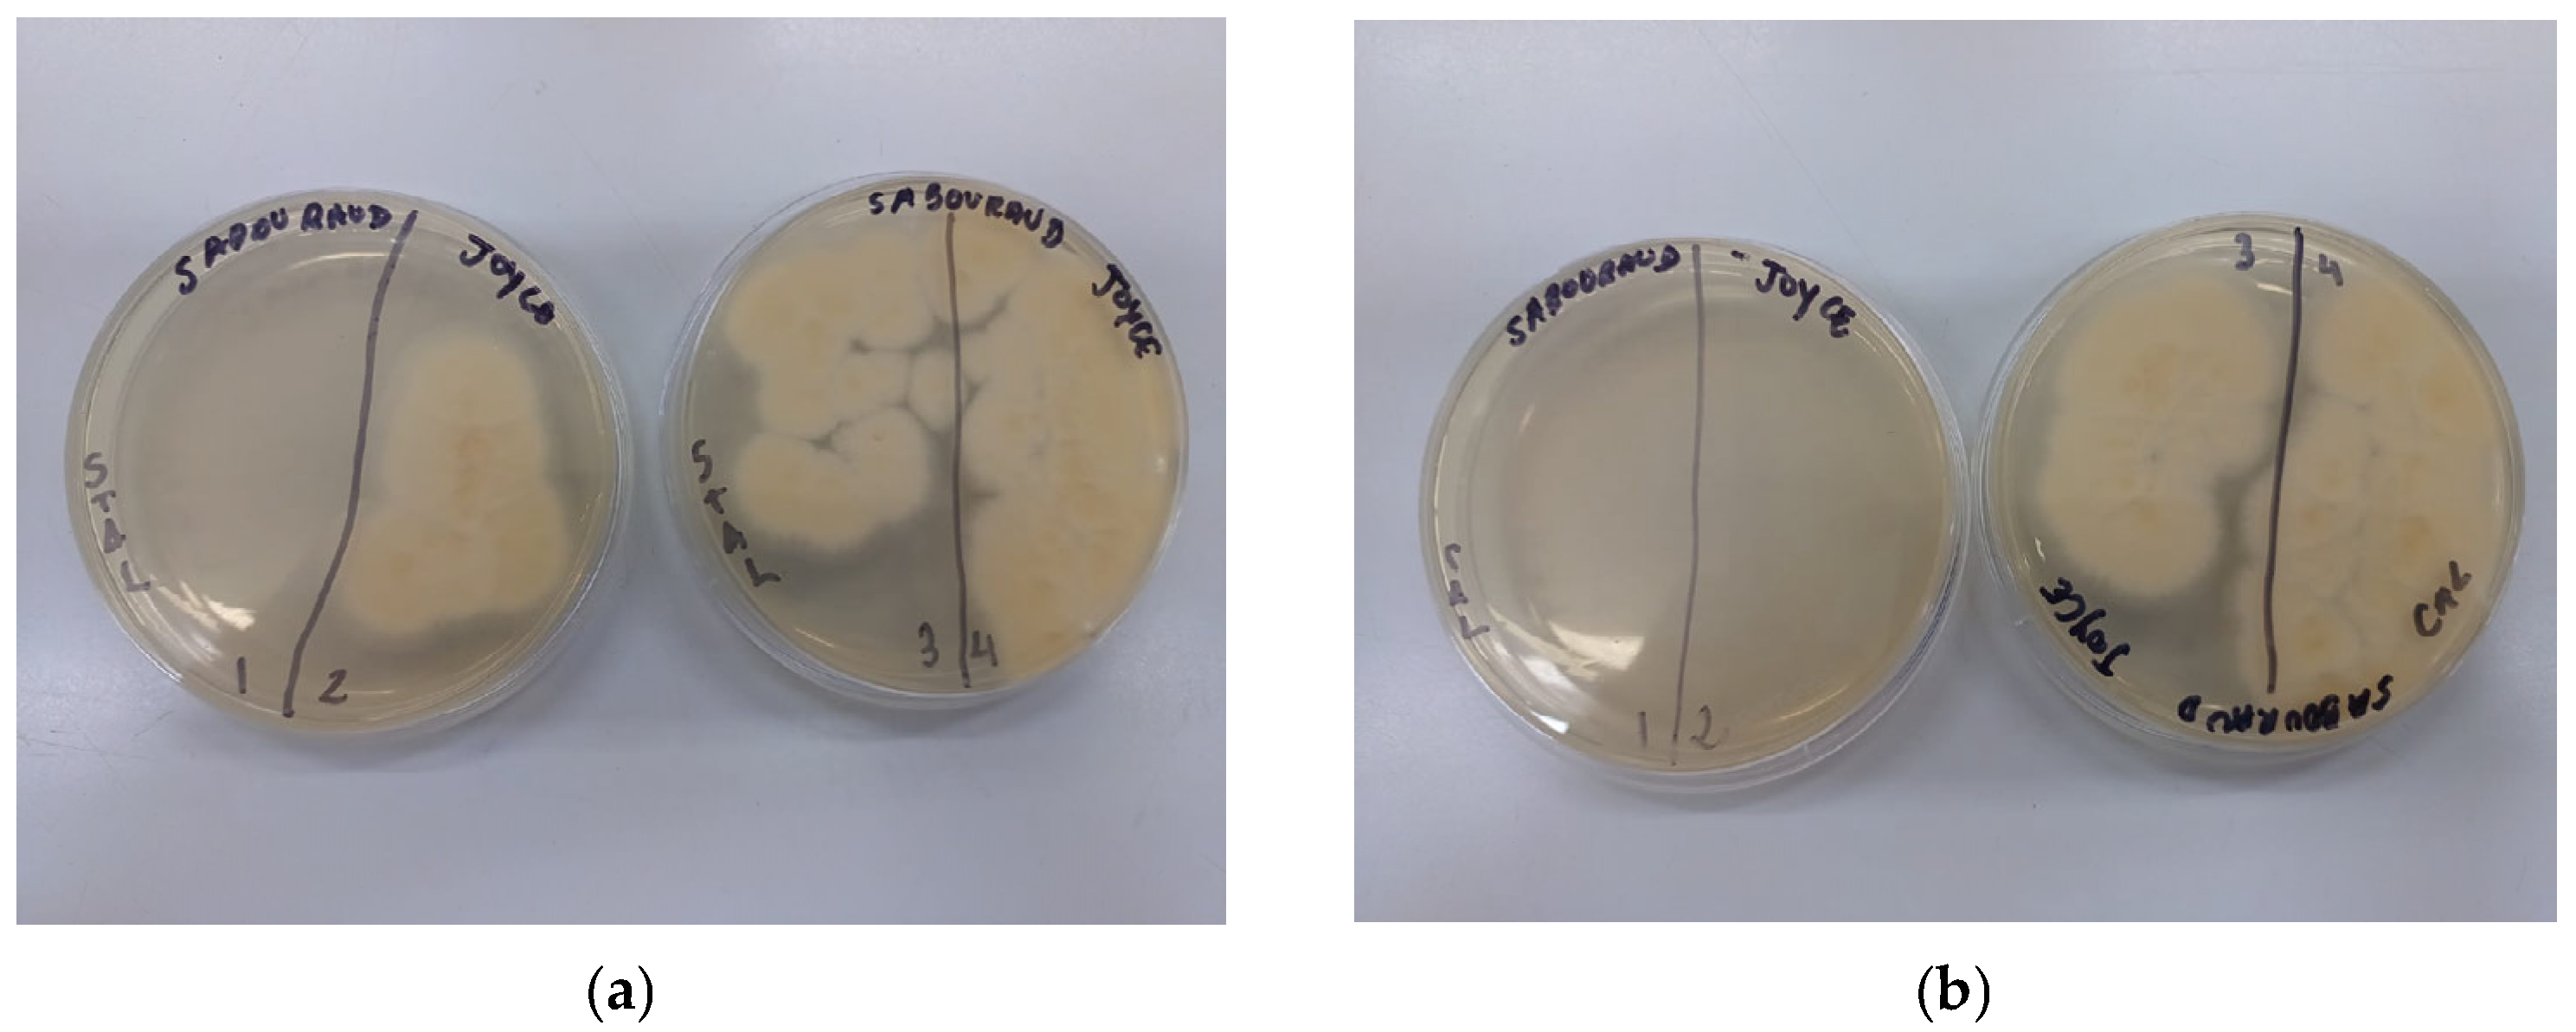
Poultry 04 00024 g001

Antibacterial and Antifungal Effects of Chemical Additives Used in Poultry Production: An In Vitro Minimum Inhibitory Concentration Study
Abstract
1. Introduction
2. Materials and Methods
3. Results
3.1. Bacterial Species
3.2. Fungal Species
4. Discussion
5. Conclusions
Author Contributions
Funding
Institutional Review Board Statement
Informed Consent Statement
Data Availability Statement
Acknowledgments
Conflicts of Interest
Abbreviations
| MIC | Minimum Inhibitory Concentration |
| ATCC | American Type Culture Collection |
| BHI | Brain Heart Infusion |
| NCCLS | National Committee for Clinical Laboratory Standards |
| INCQS | Instituto Nacional de Controle de Qualidade em Saúde |
| DRCM | Clostridium Differential Broth |
| MBC | Minimum Bactericidal Concentration |
| USDA | United States Department of Agriculture |
| ADS | Sabouraud Dextrose Agar |
| RPMI | Roswell Park Memorial Institute |
| MFC | Minimum Fungicidal Concentration |
| PPE | Porcine Proliferative Enteropathy |
References
- Lopes, M.; Roll, V.F.B.; Leite, F.L.; Dai Prá, M.A.; Xavier, E.G.; Heres, T.; Valente, B.S. Quicklime treatment and stirring of different poultry litter substrates for reducing pathogenic bacteria counts. Poult. Sci. 2013, 92, 638–644. [Google Scholar] [CrossRef] [PubMed]
- Lopes, M.; Leite, F.L.; Valente, B.S.; Heres, T.; Dai-Prá, M.A.; Xavier, E.G.; Roll, V.F.B. An assessment of the effectiveness of four in-house treatments to reduce the bacterial levels in poultry litter. Poult. Sci. 2015, 94, 2094–2098. [Google Scholar] [CrossRef] [PubMed]
- Dai-Prá, M.A.; Corrêa, E.K.; Roll, V.F.; Xavier, E.G.; Lopes, D.C.N.; Lourenço, F.F.; Zanusso, J.T.; Roll, A.P. Uso de cal virgem para controle de Salmonella spp. e Clostridium spp. em camas de aviário. Cienc. Rural 2009, 39, 1189–1194. [Google Scholar] [CrossRef]
- BRASIL. Instrução Normativa n°20, de 21 de Outubro de 2016. Estabelece o Controle e o Monitoramento de Salmonella spp. nos Estabelecimentos Avícolas Comerciais de Frangos e Perus de Corte; Diário Oficial da República Federativa do Brasil: Brasília, Brazil, 2016; pp. 13–25. Available online: https://www.defesa.agricultura.sp.gov.br/legislacoes/instrucao-normativa-sda-20-de-21-10-2016,1085.html (accessed on 15 December 2024).
- European Food Safety Authority Explains Zoonotic Diseases: Zoonotic E. coli; EFSA: Parma, Italy, 2014. Available online: https://www.efsa.europa.eu/en/corporate/pub/factsheetecoli (accessed on 5 January 2025).
- European Food Safety Authority. Shiga Toxin-Producing E. coli Outbreak(s). Available online: https://www.efsa.europa.eu/en/topics/topic/shiga-toxin-producing-e-coli-outbreaks (accessed on 8 March 2025).
- Achi, O.K.; Madubuike, C.N. Prevalence and antimicrobial resistance of Staphylococcus aureus isolated from retail ready to eat foods in Nigeria. Res. J. Microbiol. 2007, 2, 516–523. Available online: https://scialert.net/abstract/?doi=jm.2007.516.523 (accessed on 15 December 2024).
- Basset, P.; Feil, E.J.; Zanetti, G.; Blanc, D.S. The evolution and dynamics of methicillin-resistant Staphylococcus aureus. In Genetics and Evolution of Infectious Diseases; Tibayrenc, M., Ed.; Elsevier: Amsterdam, The Netherlands, 2011; pp. 669–676. [Google Scholar] [CrossRef]
- Gong, Q.; Ruan, M.D.; Niu, M.F.; Qin, C.L.; Hou, Y.; Guo, J.Z. Immune efficacy of DNA vaccines based on oprL and oprF genes of Pseudomonas aeruginosa in chickens. Poult. Sci. 2018, 97, 4219–4227. [Google Scholar] [CrossRef] [PubMed]
- Walker, S.E.; Sander, J.E.; Cline, J.L.; Helton, J.S. Characterization of Pseudomonas aeruginosa isolates associated with mortality in broiler chicks. Avian Dis. 2002, 46, 1045–1050. [Google Scholar] [CrossRef] [PubMed]
- Byrd, J.A.; Caldwell, D.Y.; Nisbet, D.J. The identification of fungi collected from the ceca of commercial poultry. Poult. Sci. 2017, 96, 2360–2365. [Google Scholar] [CrossRef] [PubMed]
- Khodadadi, M.; Masoumi, A. Recent drying technologies used for drying poultry litter (principles, advantages and disadvantages): A comprehensive review. Poult. Sci. 2025, 104, 104677. [Google Scholar] [CrossRef] [PubMed]
- Cook, K.L.; Rothrock, M.J., Jr.; Eiteman, M.A.; Lovanh, N.; Sistani, K. Evaluation of nitrogen retention and microbial populations in poultry litter treated with chemical, biological or adsorbent amendments. J. Environ. Mang. 2011, 92, 1760–1766. [Google Scholar] [CrossRef] [PubMed]
- Lucca, W.; Cecchin, R.; Timbola, E.; Grandin, J.; Lucca, M.S. Efeito de diferentes tratamentos químicos em cama para aves de corte. Rev. Agroamb. 2012, 4, 25–31. [Google Scholar] [CrossRef]
- Santos, F.G.; Escosteguy, P.A.V.; Rodrigues, L.B. Qualidade de esterco de ave poedeira requerida a dois tipos de tratamentos de compostagem. Rev. Bras. Eng. Agríc. Emb. 2010, 14, 1101–1108. [Google Scholar] [CrossRef]
- Ferreira, H.A.; Oliveira, M.C.; Traldi, A.B. Effect of chemical conditioners in the poultry litter on the broiler performance. Arq. Bras. Med. Vet. Zootec. 2004, 56, 542–546. [Google Scholar] [CrossRef]
- Roll, V.F.B.; Lopes, L.L.; Gonçalves, F.M.; Anciuti, M.; Leite, F.L.; Corrêa, E.K.; Xavier, E.G. Broiler breeder microbiological litter condition following treatment with Impact P®. Cienc. Rural 2008, 38, 2650–2653. [Google Scholar] [CrossRef]
- NCCLS Document M7-A6; Methods for Dilution Antimicrobial Susceptibility Tests for Bacteria That Grow Aerobically; Approved Standard-Sixth Edition. NCCLS: Eayne, PA, USA, 2003; ISBN 1-56238-486-40.
- NCCLS Standard M27-A2; Reference Method for Broth Dilution Tests for the Determination of Sensitivity to Antifungal Therapy of Yeasts; Approved Standard-Second Edition. NCCLS: Wayne, PA, USA, 2002; ISBN 1-56238-469-4.
- NCCLS Document M38-A; Reference Method for Broth Dilution Tests for the Determination of Sensitivity to Antifungal Therapy of Filamentous Fungi; Approved Standard. NCCLS: Wayne, PA, USA, 2002; ISBN 1-56238-470-8.
- Santurio, M.J.; Santurio, D.F.; Pozzati, P.; Moraes, C.; Franchin, P.R.; Alves, S.H. Atividade antimicrobiana dos óleos essenciais de orégano, tomilho e canela frente a sorovares de Salmonella de origem avícola. Cienc. Rural 2007, 37, 803–808. [Google Scholar] [CrossRef]
- Rothrock, M.J.K., Jr.; Cook, L.; Warren, J.G.; Sistani, K. The Effect of Alum Addition on Microbial Communities in Poultry Litter. Poult. Sci. 2008, 87, 1493–1503. [Google Scholar] [CrossRef] [PubMed]
- Oliveira, M.C.; Almeida, C.V.; Andrade, D.O.; Rodrigues, S.M.M. Teor de Matéria Seca, pH e Amônia Volatilizada da Cama de Frango Tratada ou Não com Diferentes Aditivos. R. Bras. Zootec. 2003, 32, 951–954. [Google Scholar] [CrossRef]
- Burguess, R.P.; Carey, J.B.; Shafer, D.J. The impact of pH on nitrogen retention in laboratory analysis of broiler litter. Poult. Sci. 1998, 77, 1620–1622. [Google Scholar] [CrossRef] [PubMed]
- Line, J.E.; Bailey, J.S. Effect of on-farm litter acidification treatments on Campylobacter and Salmonella populations in commercial broiler houses in northeast Georgia. Poult. Sci. 2006, 85, 1529–1534. [Google Scholar] [CrossRef] [PubMed]
- Wattanaphansak, S.; Singer, R.S.; Isaacson, R.E.; Deen, J.; Gramm, B.R.; Gebhart, C.J. In vitro assessment of the effectiveness of powder disinfectant (Stalosan® F) against Lawsonia intracellularis using two different assays. Vet. Microbiol. 2009, 136, 403–407. [Google Scholar] [CrossRef] [PubMed]
- Ghannoum, M.A.; Rice, L.B. Antifungal Agents: Mode of Action, Mechanisms of Resistance, and Correlation of These Mechanisms with Bacterial Resistance. Clin. Microbiol. Rev. 1999, 12, 501–517. [Google Scholar] [CrossRef] [PubMed]
| Commercial Additive | Recommended Dose (kg/m2) | Application Surface | Source |
|---|---|---|---|
| Quicklime | 0.60 | Litter | Dai-Prá et al., 2009 [3] |
| AvianControl® | 0.50 | Litter | Produtos Quimicos Guaçu |
| Stalosan® F | 0.05 | Litter, walls, and curtains | San Vet Holding GmbH |
| Microdilution | Microplate Well nº | Tested Concentration (%) | Application to Facilities (kg/m2) 2 |
|---|---|---|---|
| 1 1 | Not applicable | 100 1 | 10 |
| ½ | 1 | 50 | 5 |
| ¼ | 2 | 25 | 2.5 |
| 1/8 | 3 | 12.5 | 1.25 |
| 1/16 | 4 | 6.25 | 0.62 |
| 1/32 | 5 | 3.12 | 0.31 |
| 1/64 | 6 | 1.56 | 0.15 |
| 1/128 | 7 | 0.78 | 0.07 |
| AvianControl® | Stalosan® F | Quicklime | ||||
|---|---|---|---|---|---|---|
| Species | MIC | MBC | MIC | MBC | MIC | MBC |
| E. coli | - | ≥1.25 | ≥2.50 | ≥5.00 | ≥1.25 | ≥5.00 |
| S. Enteritidis | ≥0.62 | ≥1.25 | ≥2.50 | ≥5.00 | - | ≥1.25 |
| S. Infantis | - | ≥1.25 | ≥5.00 | - | ≥2.50 | ≥5.00 |
| S. Hildelberg | ≥0.62 | ≥1.25 | ≥2.50 | ≥5.00 | - | ≥5.00 |
| S. aureus | ≥0.62 | ≥1.25 | ≥5.00 | - | ≥0.62 | ≥1.25 |
| P. aeruginosa | - | ≥0.62 | ≥5.00 | - | ≥2.50 | - |
| C. perfringens | - | ≥0.31 | ≥0.31 | ≥0.62 | ≥2.50 | ≥5.00 |
| AvianControl® | Stalosan® F | Quicklime | ||||
|---|---|---|---|---|---|---|
| Species | MIC | MFC | MIC | MFC | MIC | MFC |
| Candida albicans | ≥0.15 | ≥0.31 | - | ≥1.25 | - | ≥2.50 |
| Aspergillus flavus | ≥5.00 | - | - | ≥5.00 | - | ≥2.50 |
| Penicillium citrinum | ≥5.00 | - | ≥1.25 | ≥2.50 | - | ≥2.50 |
Disclaimer/Publisher’s Note: The statements, opinions and data contained in all publications are solely those of the individual author(s) and contributor(s) and not of MDPI and/or the editor(s). MDPI and/or the editor(s) disclaim responsibility for any injury to people or property resulting from any ideas, methods, instructions or products referred to in the content. |
© 2025 by the authors. Licensee MDPI, Basel, Switzerland. This article is an open access article distributed under the terms and conditions of the Creative Commons Attribution (CC BY) license (https://creativecommons.org/licenses/by/4.0/).
Share and Cite
Furlan, J.d.J.M.; Santos, M.L.; Godoy, S.H.S.d.; Sousa, R.L.M.d. Antibacterial and Antifungal Effects of Chemical Additives Used in Poultry Production: An In Vitro Minimum Inhibitory Concentration Study. Poultry 2025, 4, 24. https://doi.org/10.3390/poultry4020024
Furlan JdJM, Santos ML, Godoy SHSd, Sousa RLMd. Antibacterial and Antifungal Effects of Chemical Additives Used in Poultry Production: An In Vitro Minimum Inhibitory Concentration Study. Poultry. 2025; 4(2):24. https://doi.org/10.3390/poultry4020024
Chicago/Turabian StyleFurlan, Joyce de Jesus Mangini, Melina Lima Santos, Silvia Helena Seraphin de Godoy, and Ricardo Luiz Moro de Sousa. 2025. "Antibacterial and Antifungal Effects of Chemical Additives Used in Poultry Production: An In Vitro Minimum Inhibitory Concentration Study" Poultry 4, no. 2: 24. https://doi.org/10.3390/poultry4020024
APA StyleFurlan, J. d. J. M., Santos, M. L., Godoy, S. H. S. d., & Sousa, R. L. M. d. (2025). Antibacterial and Antifungal Effects of Chemical Additives Used in Poultry Production: An In Vitro Minimum Inhibitory Concentration Study. Poultry, 4(2), 24. https://doi.org/10.3390/poultry4020024

